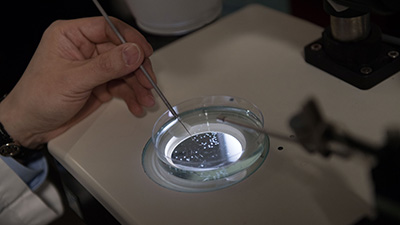
Accelerate Research donate to the CRM

Mass General Research Institute
Center for Regenerative Medicine
The Center for Regenerative Medicine at Massachusetts General Hospital is dedicated to understanding how tissues are formed and may be repaired in settings of injury and disease.


About This Center
The Center for Regenerative Medicine (CRM) at Massachusetts General Hospital was launched in 2004 in recognition of the great medical potential of stem cell research.
About Stem Cells
Information about stem cells and regenerative medicine for students, patients and the general public.
Our Team
Learn about our faculty and staff and the labs we run.
Accelerate Research
How you can help accelerate research and discovery by supporting the Center for Regenerative Medicine.
Core Facilities
The core facilities at the Center for Regenerative Medicine provide essential services in flow cytometry, light microscopy and image analysis.